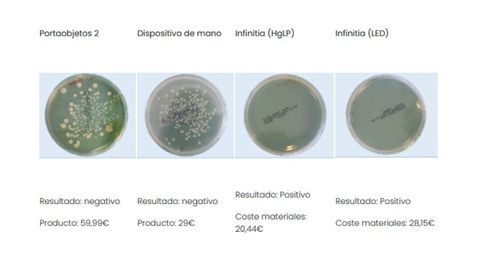

Desinfectar con luz UV en casa: ¿es eficaz? Analizamos cuatro dispositivos

En 2020, todo tipo de dispositivos relacionados con la desinfección mediante el ozono y la radiación ultravioleta han inundado el mercado. Estas dos potentes tecnologías -ahora tan en tendencia- son, sin embargo, viejas conocidas: durante décadas se han utilizado en multitud de aplicaciones industriales, no solo en desinfección.
Eso sí, la pandemia de la COVID ha ocasionado que el mercado se haya reconducido hacia el consumidor final, que no tiene forma de comprobar la veracidad de su eficacia y queda, por tanto, expuesto a “medias verdades”.
En este artículo tratamos de arrojar algo de luz sobre la eficacia de algunas de las lámparas UV de desinfección a nuestro alcance en portales web de la mano de Infinitia, startup industrial que presta servicios de ingeniería e I+D.
Los investigadores han testeado directamente productos de desinfección con luz ultravioleta de fácil acceso en el comercio online, cuyo reclamo es siempre el mismo: desinfecciones superiores al 99,9 % es unos pocos minutos (o segundos) que dan una sensación de confort y bienestar. ¿Cumplirán con lo que anuncian?
Las lámparas UV-C han inundado los comercios electrónicos con la promesa de una desinfección rápida y permanente. Sin embargo, no es tan simple.
Lámparas UV-C a nuestro alcance: ¿Son todas eficaces?
El objetivo era comprobar cómo de eficaces eran estas luces ultravioletas desinfectantes en términos de higienización de superficies. Para ello, el experimento ha contado con los siguientes cuatros dispositivos adquiridos en Amazon, teniendo en cuenta criterios como el precio, la valoración media de los compradores y las especificaciones técnicas.

En primer lugar, se realizó un ensayo físico para averiguar la naturaleza e intensidad de la radiación ultravioleta. Hay que tener en cuenta que cualquier tipo de luz no desinfecta, sino que debe tener una energía suficiente para producir modificaciones químicas en el ADN de los microorganismos.
Este valor se puede determinar mediante la longitud de onda. Además de esto, ha de haber suficiente intensidad o flujo: del mismo modo que no podemos iluminar un campo de futbol con una bombilla, no podemos desinfectar una superficie muy amplia con unos pocos LED.
La naturaleza de las radiaciones es muy compleja y no siempre es posible determinar cómo interacciona con los microorganismos. Es por esto que, además de la caracterización energética, es necesario realizar ensayos de microbiología para conocer cuál es el resultado tras utilizar estos productos que prometen la desinfección con luz ultravioleta.
La única forma de comprobar la eficiencia de estos productos es realizar ensayos radiométricos y microbiológicos
Ensayos radiométricos: ¿existe una reducción significativa de microorganismos?
La siguiente grafica muestra la composición espectral de cada dispositivo, como su huella dactilar, y el espectro de absorción del ADN (en rojo). La idea fundamental es que la fuente de luz emita en la misma zona donde el ADN absorbe energía (zona azul).
Todos los productos tienen un pico en la zona 350-450 nm, que es el motivo por el que nuestros ojos perciben el color violeta y, tan solo dos de ellos, tienen un pequeño pico alrededor de 265 nm. Esta última banda es la responsable de la desinfección y, como se puede ver, es la menos intensa o, en algún caso, está ausente. Además, esta luz es invisible para los ojos humanos y no la podemos detectar a simple vista.

Según los expertos de Infinitia, con estos resultados ya podríamos asegurar que o bien no habrá una reducción significativa de microorganismos o que será muy baja. Además, su eficiencia energética es muy baja.
Ensayos con bacterias (microbiológicos): dentro del laboratorio
El método de aplicación se realizó según a las instrucciones provistas en cada producto. Cuando no estaban indicadas, se procuró aplicar las mejores condiciones posibles, aunque no fueran las que un usuario aplicaría en la vida real. Tras el tratamiento, se cultivaron las bacterias en un medio de crecimiento para comprobar si había reducción de carga microbiana.
En el primer dispositivo, siguiendo las indicaciones de la página web, los investigadores decidieron tratar de desinfectar una mascarilla quirúrgica con los portaobjetos durante 10 minutos. Una mitad fue irradiada y la otra mitad usada para un cultivo de referencia.
En el caso de la lámpara de mano, se utilizó la configuración de “desinfección profunda” a una distancia de 1 centímetros durante 30 segundos (tiempo según instrucciones).
Además, los expertos de Infinitia diseñaron su propio escenario para comparar los resultados con productos estudiados. De esta forma, utilizaron dos montajes, uno con lámparas tradicionales de mercurio (HgLP) y otro con tecnología LED, lo más novedosos del mercado. Para esto calcularon la distancia y tiempo de aplicación necesarios para suministrar una irradiancia que permitiera el 99,99% de reducción bacteriana, que es el resultado mínimo para hablar de desinfección. El tratamiento con la lampara fluorescente fue de 1 minuto mientras que en los LED fue de 5 minutos.

Ninguno de los productos arrojó un resultado de desinfección
En estos experimentos, ninguno de los productos utilizados arrojó un resultado de desinfección, a diferencia de los sistemas preparados por los expertos, en los que no se observó ningún crecimiento de microorganismos después de la incubación de las muestras tratadas.
Como indicamos al principio, la radiación ultravioleta es una tecnología madura ampliamente utilizada que presenta claras ventajas como la versatilidad de aplicación y la inactivación de bacterias súper resistentes. A la vista de los resultados, se demuestra que tienen capacidad para desinfectar. Sin embargo, como insisten desde la empresa de ingeniería e I+D es necesario calcular y diseñar cada caso de uso de forma adecuada para tener éxito. Por ello, desde Infinitia recomiendan encarecidamente huir de este tipo de productos y ponerse siempre en manos de personal cualificado, tanto por su seguridad como por los resultados.